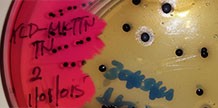
Latest news image

Huduma Zetu
-
Training, Reaseach & Consultancy
Centre for Training, Research and Consultancy
... -
Microbiology Test
The NFQCL-Nyegezi offers Microbiological tests at affordable costs.
... -
Chemical Test
The NFQCL- Nyegezi offers Chemical tests at affordable costs.
... -
Inspection Service
The Inspection Services Section
...
-
PESTICIDE MONITORING OF LAKE VICTORIA (Soil and Water)
Sep 19, 2018
Lake victoria monitoring .....Sampling for sediment and water (inshore & offshore)
-
MAAFISA TOKA KITENGO CHA FEDHA ZA NJE
Mar 22, 2018
Wizara ya fedha na uchumi
-
SADCAS ASSESSORS
Nov 13, 2017
Group photo with SADCAS Assessors.